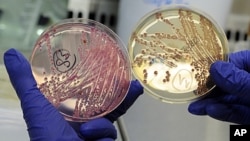

世界卫生组织说,在欧洲导致18人死亡的大肠杆菌是独一无二的新菌株,以前从未在感染大肠杆菌的病人身上发现。
世卫组织6月2日(星期四)说,初步的基因测试显示 ,导致这次疫症爆发的高度传染菌株可能是两种不同大肠杆菌的基因重组。分析德国疫症爆发的中国科学家证实,这种细菌突变从来没有出现在先前的感染病例中。
这次疫症爆发是现代史上最为致命的大肠杆菌感染病症,而且从感染细菌而生病的人数来看也是有史以来的第二位或者第三位。世卫组织的食品安全专家克鲁斯说,这种致命菌株具有多种特性,使它比其它菌株毒性更强。在欧洲十一个国家,已经有1600多人由于这种迅速传播的细菌感染而患病,而德国是受感染和死亡人数最多的国家。
卫生官员一直无法找到疫情爆发的原因或起源。但是同类的感染主要来自细菌污染的食物。由于不能确定最近疫症爆发的起因,人们对欧洲的农产品的担忧在不断蔓延。
星期四,阿拉伯联合酋长国禁止进口来自西班牙、德国、丹麦和荷兰的黄瓜。俄罗斯说,它禁止从欧盟进口所有新鲜蔬菜。欧盟立即称这一行动“过激”。
欧盟去年向俄罗斯出口了价值8.53亿美元的蔬菜。欧盟表示,它将要莫斯科作出解释。俄罗斯说,当局将扣押已经从欧盟国家进口的蔬菜。俄罗斯的消费者保护机构负责人根纳季.奥尼先科敦促俄罗斯人“不要食用进口蔬菜,而要选择国内产品”。
中国时间 6:10 2025年10月21日 星期二